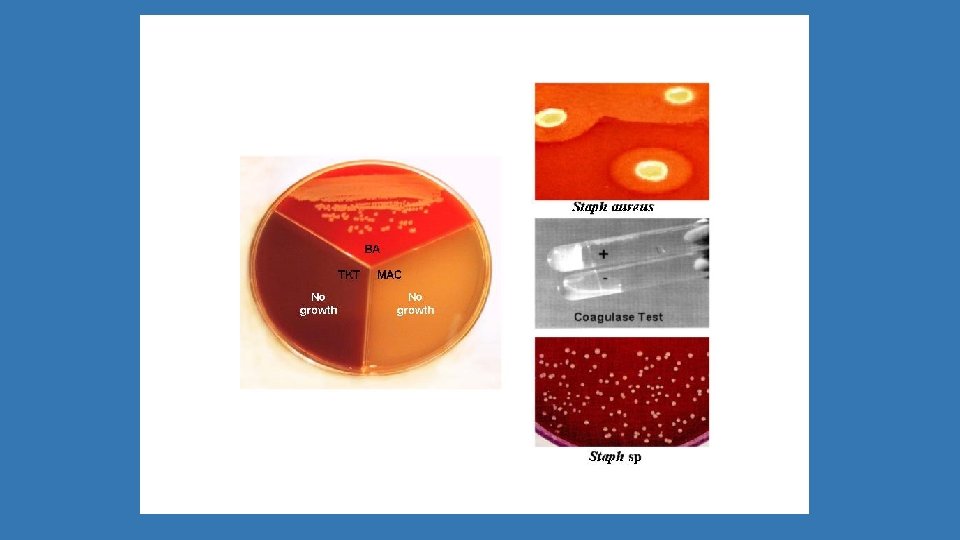

GNERO STAPHYLOCOCCUS Se clasifican segn la produccin de

- Slides: 75
GÉNERO STAPHYLOCOCCUS
Se clasifican según la producción de catalasa (desdobla el H 2 O 2). CATALASA (+) MICROCOCCACEAE (–) STREPTOCOCCACEA Staphylococcus spp Micrococcus spp Streptococcus spp Enterococcus spp
Coloración de Gram: Por el color, la morfología y la disposición.
ESTAFILOCOCOS TAXONOMIA Manual de Bergey 1986 Familia Micrococcaceae • Genero I Planococcus • Genero II Micrococcus • Genero III Stomatococcus • Genero IV Staphylococcus
ESTAFILOCOCOS ESPECIE • S. aureus • S. epidermidis • S. saprophyticus • S. haemolyticus • S. lugdunensis • S. schleiferi • S. saccharolyticus • S. warneri • S. hominis • S. auricularis • S. xylosus • S. simulans • S. capitis • S. cohnii CAUSA DE ENFERMEDAD Común Infrecuente Rara Rara
ESTAFILOCOCOS MORFOLOGIA • Células esféricas • Pueden estar aislados, en pares, tétradas o racimos • No móviles, no esporulados
Staphylococcus spp • Coagulasa variables • Son crecimiento Sondedefácil crecimiento • Anaerobios facultativos (Ex. S. • Crecen comunes Crecenenenmedios comunes saccharolyticus) tanto sólidos como líquidos • Catalasa + • Cápsula – • Oxidasa • O/F de glucosa: Fermentativo • T optima: 30 -37ºC
ESTAFILOCOCOS • Actualmente 44 especies, 17 encontradas en muestras clínicas humanas • Responsable del 80% de las infecciones piógenas humanas • Ocupa el 2 do lugar como germen causal de infecciones nosocomiales • Staphylococcus aureus es el patógeno más importante de la familia • Entre los coagulasa negativos los mas comunes son S epidermidis y S saprophyticus
Genero Staphylococcus • Comensal de piel y mucosas, en especial de vías digestivas y respiratorias superiores. Biota habitual de nasofaringe y región perineal • Del griego Staphy “racimos
ESTAFILOCOCOS Producen pigmentos blanco al amarillo intenso
Staphylococcus aureus. Estructura antihigiénica Peptidoglicano Polisacárido A • Específicos para la especie • Constituido por acido teicoico Proteína A • Componente de la pared celular. • Es especifica para la especie • Se une a la porción Fc de las Ig. G • Se usa en el lab para identificar S aureus Antigenos capsulares • Menos frecuentes • Poseen actividad antifagocitica PROTEÍNA A + Anticuerpo específico + antígeno
Staphylococcus aureus: factores de virulencia ENZIMAS • Coagulasa • Catalasa • Hialuronidasa • Fibrinolisina • Lipasa • Nucleasa • Penicilinasa TOXINAS • Citolisinas(α, β, γ, leucocidinas) • Exfoliativa (epidermolítica) • Síndrome Shock tóxico • Enterotoxinas (A-I) OTROS • Producción de Limo • Cápsula • Pared celular
HEMOLISINAS • Hemolisinas (citolisinasaaaaaaa 0: a, b, g, d • Todas tienen características antigénicas distintas
Productos Extracelulares Enterotoxinas A, B, C, C 1, C 2, C 3, D, E, H e I: • Proteínas extracelulares compuestas de cadenas polipeptídicas. • Resistentes al calor (100ºC/30 min) Toxina A: • Producción favorecida en flanes, leche cruda, crema, helado, salsas, pescado. • Importantes en las intoxicaciones alimenticias Toxina B • Produce colitis seudomembranosa Toxina Cy D • Se detecta en productos lacteos • Causa nauseas, vómitos y diarreas
Toxinas y enzimas • Lipasa: Enzima que degrada los ácidos grasos presentes en los tejidos cutáneos sanos causando abscesos. Contribuyen a la difusión local • Estafiloquinasa: actúa sobre la fibrina • Leucocidina: lisa granulocitos y macrófagos (LSPV) • Hialuronidasa: factor de propagación
Enzimas y toxinas • -Lactamasa: Responsable de la resistencia a la penicilina porque la hidroliza. • Exfoliatina: producidas por 10% de SAU. Son 2 A y B. Actúan sobre la piel. Dermatitis exfoliativa. Mayor frecuencia en niños de corta edad.
• Toxina TSST-1: 1. 2. 3. Causante del síndrome del shock tóxico letal. Está codificada a nivel cromosomal y pertenece a la familia de los superantígenos. Ejercen su efecto mediante la formación de un puente o unión inespecífica entre las moléculas MHC II de las células presentadores de antígeno y los receptores de las células T. Esto provoca la estimulación de un gran número de linfocito T, liberándose una cantidad excesiva de citoquinas. 4.
ESTAFILOCOCOS
DISTRIBUCIÓN Y TRANSMISIÓN: • Por contacto directo • Puede diseminarse de la cepa endógena a sitios estériles o persona a persona por fomites • Puede transmitirse a partir de una lesión cutánea infectada de un profesional de la salud al paciente • PATOGÉNESIS: Sobrepasa las barreras de defensas cutáneas y mucosas, invaden tejidos, producen abscesos, pústulas y siguiendo la vía sanguínea o linfática, septicemia. • Pueden por sus toxinas causar intoxicación alimentaria Absceso: colección limitada de pus. Pústula: elevación cutánea llena de pus
Factores predisponentes del huésped • Destrucción de epidermis o mucosas (quemados, picaduras, heridas). S. aureus. • Infecciones por virus (Ej. : neumonía). • Presencia de cuerpos extraños (catéteres, prótesis, válvulas cardíacas, diálisis) • Diabetes mellitus (acidosis metabólica descompensada por alteraciones de la fagocitosis). • Neutropenia (en pacientes con enfermedades malignas tratados con drogas citotóxicas). • Alteración de la flora normal (tratamientos con antibióticos innecesarios).
• Grupos de riesgo: • 1. Infecciones asociadas a cuerpos extraños: catéteres, shunts, válvulas cardíacas protésicas, prótesis osteoarticulares, diálisis, cable de marcapasos, implantes mamarios, lentes intraoculares, sondas vesicales. Estas infecciones son posibles porque producen un exopolisacárido. Esta es una barrera de permeabilidad tanto para antibióticos como para fagocitos. Muchas de estas infecciones no se curan con antibióticos sino que hay que remover el cuerpo extraño. • 2. Sepsis en pacientes neutropénicos. • 3. Sepsis en neonatos prematuros.
Cuadros clínicos • • • Infecciones supurativas. Abscesos, panadizos, flemones, celulitis Osteomielitis Septicemia Pioderma Mastitis Infecciones urinarias Enterocolitis Neumonía. Empiema Endocarditis aguda Adenitis Sepsis Flemón: inflamación del tej subcutaneo que tiende a extenderse Panadizos: Inflamación flemonosa de un dedo Pioderma: Dermatosis supurativa
Cuadros clínicos • Impetigo • Síndrome de la piel escaldada • Intoxicación alimentaria: PI: 1 -8 h. Nauseas, vómitos, diarrea, deshidratación grave y shock. Enterotoxinas • Escarlatina estafilococica • Artritis • Otitis media aguda • Fascitis necrotizante
PIODERMAS: Las foliculitis se clasifican como: • foliculitis superficiales, • forúnculos que se presentan como nódulos inflamatorios más profundos y • ántrax o carbunco, cuando las lesiones son más amplias.
Infecciones cutáneas estafilocócicas • Foliculitis superficial con formación de pústulas elevadas en forma de cápsula en torno al folículo piloso
foliculitis • Bacterias tienen acceso a piel a través de folículo y establecen infección leve en epidermis que rodea el conducto folicular. • Portadores de S. aureus en la piel son más susceptibles a la enfermedad. • Lesiones consisten en pequeñas pápulas o pústulas frágiles, blanco amarillentas, rodeadas por una banda estrecha de eritema, aparecen por brotes y curan en unos pocos días • Son lesiones individuales y no se hacen confluentes, Pápula: elevación eruptiva pequeña, sólida, circunscripta de la piel, que termina en descamación
Infecciones cutáneas estafilocócicas • Foliculitis profunda el microorganismo invade la porción profunda del folículo y la dermis
Infecciones cutáneas estafilocócicas Forúnculo: • Es una infección profunda del folículo piloso caracterizado por un nódulo inflamatorio doloroso alrededor del orificio piloso que luego se absceda. • Nódulo duro a la palpación, redondeado, rojo brillante, caliente, muy doloroso, que origina luego una pústula y un tapón necrótico en su centro. Nódulo: pequeña eminencia , nudosidad o vegetación
• Infección profunda de un conglomerado de furúnculos • Acompañada de fiebre, anorexia, astenia, dolor intenso • Fenómenos tóxicoinfecciosos, localizado principalmente en la nuca y parte superior de la espalda, de evolución prolongada y cicatrización lenta. • Se observa en diabéticos, desnutridos, obesos, adictos a drogas o con dermatosis severas generalizadas ANTRAX Antrax
Infecciones cutáneas estafilocócicas Antrax
Antrax
Infecciones de piel y partes blandas Las infecciones de la piel se pueden clasificar según el estrato afectado: estrato córneo: impétigo epidermis: ectima dermis superficial: erisipela dermis profunda: linfangitis grasa subcutánea: celulitis
Infecciones cutáneas estafilocócicas Impétigo vulgar • Se caracteriza por lesiones indolorosa, pruriginosas y con moderada sensibilidad a la palpación, sin eritema alrededor • Lesión comienza como un grupo de ampollas pequeñas que revientan, seguido de supuración y formación de una costra gruesa, color café o miel, que se adhiere firmemente a la piel. • El paciente con ausencia de signos y síntomas sistémicos, buen estado general, habitualmente afebril • Es frecuente la presencia de linfadenopatía regional en el 90% de los casos Cuello de un niño de 2 años de edad
Impetigo Puede iniciarse con una sola mácula eritematosa de 2 a 4 mm que rápidamente evoluciona a vesícula o pústula Macula: lesión cutánea que consiste en una mancha roja que no se eleva de la piel
Impetigo
Impetigo ampollar • Se presenta en neonatos • Brotes epidémicos en salas de hospitalización y UCIN • Presenta pequeñas o grandes ampollas superficiales, frágiles, en tronco y extremidades, en un segmento corporal o diseminadas • Complicación frecuente de la varicela. • Ampollas superficiales sobre piel sana, sin halo eritematoso, contenido turbio, transparente o purulento en grupos de 3 a 6, que al romperse dejan una escama en collarete, rojiza que seca rápidamente, evolucionando a costra de color barniz. • Son autoinoculables y contagiosas a otros niños
Síndrome de piel escaldada • Es una dermatosis aguda propia de los menores de 5 años. • El cuadro clínico se caracteriza por fiebre, eritema y desprendimiento epidérmico generalizado, similar a una quemadura. • Está producido por una exotoxina, la exfoliatina, responsable de la separación de la capa granulosa epidérmica que provoca ampollas.
Infecciones cutáneas estafilocócicas • Síndrome de piel escaldada en un prematuro de una semana de edad
Infecciones cutáneas estafilocócicas • Síndrome escaldada de piel
Ectima El ectima • Es una infección bacteriana ulcerativa de la piel similar al impétigo, pero más profundamente invasivo (invade la dermis) que éste, caracterizado clínicamente por una vesícula o pústula que evoluciona hacia la formación de una úlcera cubierta de una costra amarillenta, de curso crónico y que cura en forma lenta
Conjuntivitis
Piodermitis
Cuadros clínicos. SST • Síndrome del shock toxico: fiebre, eritrodermia generalizada, edema, hipotension mialgia, conjuntivitis y fallo renal. • Causado por la toxina • Aunque los primeros casos descritos comprometían principalmente a mujeres que utilizaban tampones durante sus períodos (menstruación), sólo el 55% de los casos actuales se asocian con la menstruación. • Esta enfermedad también se puede presentar en niños, en mujeres posmenopáusicas y en hombres.
SST placa eritematosa que posteriormente se torna de color púrpura ó negruzco con áreas bullosas sobre la superficie, instancia en que se inicia el proceso necrótico francamente devastador
Celulitis Inflamación aguda y diseminada del tejido celular subcutáneo
Fascitis necrotizante compromete el tejido celular subcutáneo y la fascia.
SAMR hospitalarios: cepas del mismo paciente O introducidas por las manos del medico. R a multiples Atb. SAMR de la comunidad: Clones peculiares en pacientes sin factores de riesgo. R a oxa Pero S a resto de atb Absceso causado por SAMR
VISA • S aureus Intermedio o Resistente a Vancomicina • Qué incrementa mi riesgo de adquirir una infección por VISA? • Antibióticos • Estancia hospitalaria: • Implantes metalicos, tubos o lineas. • Pobre higiene • Sistema inmune débil: diabetes o enfermedad de los riñones. Haber tenido cirugías o transplante de órganos
Staphylococcus epidermidis • Los estafilococos coagulasa (-) son gérmenes habituales de piel. • Casi el 100% de las personas los portan en su flora normal.
ESTAFILOCOCOS S. haemolyticus y S. lugdunesis • Biota normal, similar a S. epidermidis pero en menor cantidad S. saprophyticus • Biota habitual de piel humana y mucosa de aparato genitourinario • Puede causar Infecciones urinarias en mujeres sexualmente activas. • Cuando se aísla en niños de más de 5 años puede ser marcador de abuso sexual. • Endocarditis en válvulas nativas (>del 5%). • No es considerado agente de infecciones nosocomiales
ESTAFILOCOCOS Staphylococcus epidermidis • Biota habitual de piel y mucosas humanas • Puede diseminarse a un sitio normalmente estéril, casi siempre resultado de implante de dispositivos médicos • La diseminación de persona a persona en los hospitales puede provocar la colonización de los pacientes
“Slime” o biofilms Es un glucoconjugado viscoso extracelular que permiten que estas bacterias se adhieran a las superficies lisas como dispositivos protésicos, catéteres. • CÉLULA BACTERIANA QUE PRODUCE UNA CAPA DE “SLIME” (LIMO)
Biofilms sobre un catéter endovenoso formado por S. epidermidis con “slime”. Esto facilita la adherencia al caréter de las colonias bacterianas
Diagnostico Muestras • Pus obtenido por punción • Tejidos afectados • Muestras de leche Gram Cultivo Antibiograma
Aislamiento, Cultivo y Identificación • Medios de cultivo comunes como agar sangre • Colonias en 24 horas, redondas, lisas, lustrosas, pigmentación dorada. • Gram positivos, racimos • Hemólisis
Coloración de Gram
PRUEBA DE LA CATALASA (+) H 202 H 2 O+O 2
CG+ catalasa +. Diferenciar por la coagulasa. • La coagulasa es un enzima capaz de actuar sobre el fibrinogeno al que lo transforma en fibrina. • La mayoría de las cepas de S. aureus patógenas (enterotoxigénicas) producen esta enzima. • 98% de S aureus la produce
CG+ catalasa +, diferenciar por la prueba de DNAsa. • Algunas bacterias excretan nucleasas que hidrolizan el DNA. • Se hace una estría gruesa en una placa de medio que contenga DNA. • Se revela después de incubar con HCL 0, 1 N que precipita el DNA no hidrolizado.
Prueba de Manitol salado En placas • Diferencia Staphylococcus aureus de otras especies
Estafilococos : Factores de virulencia presentes en S. aureus PRODUCTO TOXINA Exfoliativa Provoca división de los puentes intracelulares en la capa granulosa de la epidermis, originando descamación generalizada (piel escaldada) Toxina 1 (enterotoxina F) Fiebre, descamación, erupción cutánea, hipotensión. Afecta a varios sistemas. Se ha relacionado con el síndrome de Shock tóxico Enterotoxinas Provocan un cuadro emético, afectando al SNC que genera un cuadro de gastroenteritis con vómito
Estafilococos : Factores de virulencia presentes en S. aureus PRODUCTO EFECTO DE LA ENZIMA Catalasa Neutraliza los radicales libres producidos por LPMN Coagulasa Forma una capa de fibrina sobre el absceso, protegiendo de fagocitosis. Activa al complemento Hialuronidasa Hidroliza los enlaces glucosídicos del ac. hialunónico facilitando la diseminación Leucocidina Daña los leucocitos y genera granulocitopenia Hemolisina α Citotóxica para eritrocitos, leucocitos, plaquetas. Dermonecrótica. Hemolisina β Citotóxica para eritrocitos, leucocitos, macrófagos y fibroblastos Hemolisinasδ Citotóxica para eritrocitos, leucocitos (Esfingomielinasa C Hemolisinas γ Citotóxica para eritrocitos Lipasas Hidrolizan membrana celular, favorecen invasión de tejidos cutáneos y subcutáneos DNAsas Favorecen la diseminación de la bacterias β-lactamasas Confieren resistencia a los antibióticos β-lactámicos
ESTAFILOCOCOS: ESTRUCTURA Y FUNCION ESTRUCTURA FUNCION Cápsula Inhibe la opsonización y fagocitosis Peptidoglicano Estabilidad osmótica, estimula la producción de pirógenos endógenos. Inhibe la fagocitosis y la quimiotaxis. Atrae quimicamente a LPMN y la lisosima lo hidroliza. Proteína A Se une a receptores Fc de Ig. G(1, 2, 4). Inhibe la opsonización y la fagocitosis. Anticomplemento. Ac. teicoico Polisacáridos específicos de especie. Regula la concentración catiónica en la membrana celular. Receptor para bacteriófagos. Sitio de adherencia para receptores en superficies mucosas Membrana citoplásmica Barrera osmótica, regula el transporte hacia y desde la célula. Donde se encuentran localizadas las enzimas biosintéticas y respiratorias